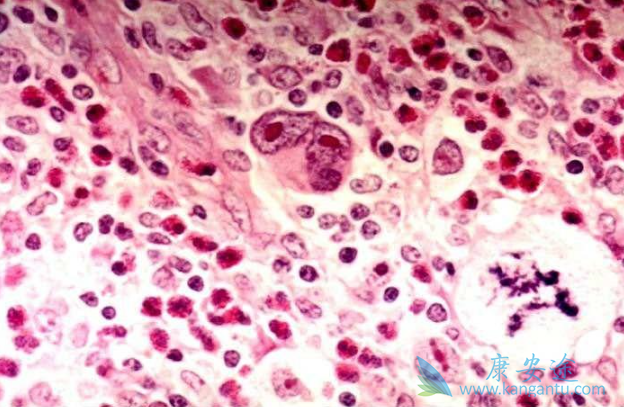
������ܰ���

现代放化疗的应用使霍奇金淋巴瘤(HL)已成为一种可治愈的肿瘤,但大量长期随诊结果显示,15年死亡率较普通人高31%,死亡原因除了复发外,第二肿瘤占11%~38%,急性心肌梗死13%,肺纤维化1%~6%。因此,对于能够被根治的HL,疗效和保证生活质量是同样值得关注的问题。
因此,通过对HL远期治疗并发症的认识,提出了防止和减少远期严重并发症、提高生存质量的治疗新策略。目前主要根据临床分期结合预后因素制定HL的治疗方案。1)单独放射治疗。目前认为,单独放射治疗仅适用于ⅠA期NLPHL患者,对其他患者,放疗仅作为化疗的辅助治疗。
2)早期(CSⅠ、Ⅱ期)预后良好的霍奇金淋巴瘤。ABVD化疗2~4程加上受累野20~30Gy放疗。3)早期(CSⅠ、Ⅱ期)预后不良的HL。ABVD化疗4~6程加上受累野或者区域20~36Gy放疗。4)晚期HL。ABVD化疗6~8程,伴有巨块者加上受累野或者区域30~36Gy放疗。5)难治或者复发病例。应该选用与原方案无交叉耐药的新方案,例如ICE、DHAP、ESHAP、mini-BEAM、GDP、ABVD/MOPP(或COPP)交替方案等进行治疗。
详情请访问 肿瘤 https://www.kangantu.com/














请简单描述您的疾病情况,我们会有专业的医学博士免费为您解答问题(24小时内进行电话回访)